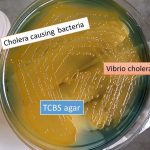
Vibrio cholerae on TCBS agar

Tag: Introduction of Thiosulfate Citrate Bile Salts Sucrose (TCBS) Agar
Thiosulfate Citrate Bile Salts Sucrose (TCBS) Agar : Introduction, Composition, Uses, Result Interpretation and Limitation
Introduction of Thiosulfate Citrate Bile Salts Sucrose (TCBS) Agar Vibrio...
Introduction of Thiosulfate Citrate Bile Salts Sucrose (TCBS) Agar Vibrio...
